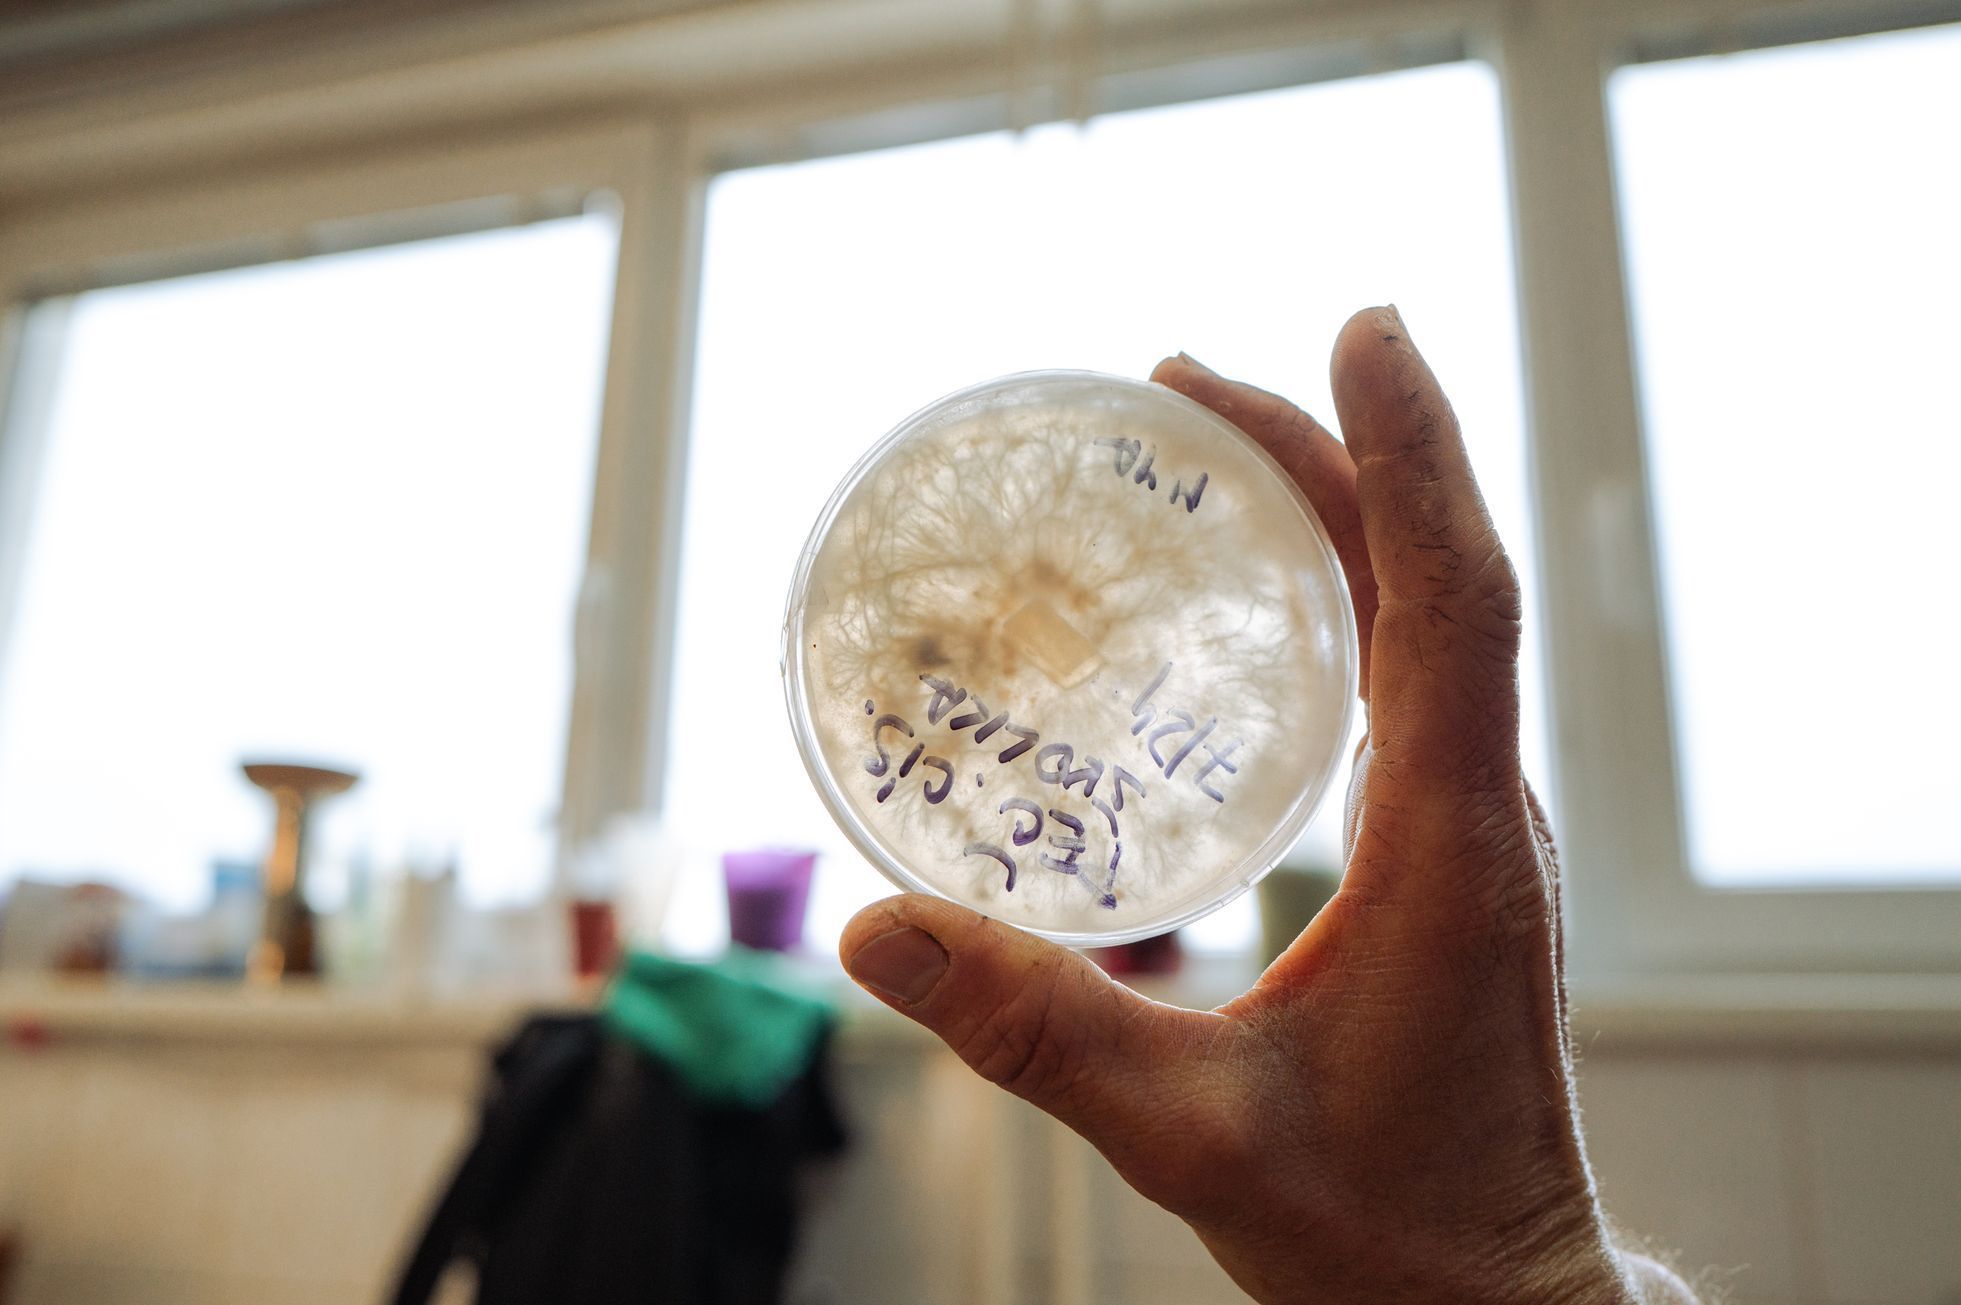

PĚSTOVÁNÍ VLASTNÍCH HUB
od ŠPALKU ke SKLIZNI
Proměňte OBYČEJNÉ ŠPALKY ve svou vlastní HOUBOVOU ZAHRADU
a sklízejte plody své práce po celý rok.
"S Jirkou Šťáskem se krok za krokem naučíte celou cestu - od výběru dřeva až po první úrodu. Získáte know-how ověřené osmiletou praxí a radost z vlastnoručně vypěstovaných hub."
Proč 80% začátečníků při pěstování hub selže?
Problémy:
- Nekvalitní sadba z marketů
- Špatně zvolené dřevo
- Nevhodné načasování
- Neznalost správných postupů
Řešení:
- Přístup ke kvalitní sadbě přímo z Jirkovi laboratořesadba je na objednání a absolventi kurzu ji mají za zvýhodněnou cenu
- Přesný návod na výběr správného dřeva
- Načasování podle jarní sezóny
- Jeho lety a praxí ověřené postupy
Vyhni se těmto nejčastějším chybám a získej ověřené know-how přímo od Jirky.
Poznejte více Jirku, znalce a milovníka hub
Jirka zasvětil život houbám a jejich tajemství. Nedávný článek na Aktuálně.cz popisuje jeho cestu od sběru hub v Bílých Karpatech, kde za jedno dopoledne nasbírá i 60 kilo hub, až po vlastní laboratoř s databankou houbových kultur z české přírody.
Ve své laboratoři pěstuje vzácné druhy jako korálovec ježatý nebo reishi. Jeho přístup spojuje tradiční moudrost s moderní vědou - a právě toto know-how vám nyní poprvé zpřístupní v tomto kurzu."
Jirku znáte také z našeho projektu Žít lehce, kdy jsem natočil jeho inspirativní příběh.
Tento dokumentární film v hodnotě 250 Kč dostanete jako bonus k variantě Hlubší poznání.
Délka dokumentu je cca 40 min.
"Moje cesta začala před 8 lety obyčejným špalkem a touhou vypěstovat vlastní houby. Dnes, po letech učení od hakímů v tureckých horách až po práci ve své laboratoři, vím, že pěstování hub je umění dostupné každému. A právě vám chci předat vše, co jsem se naučil..."
Proč je kvalitní sadba základ úspěchu?

Jirka vyrábí sadbu ve vlastní laboratoři.
Na rozdíl od běžné sadby z marketů je:
• Čerstvá a vitální
• Houbová kultura s rodokmenem
• Bez kontaminace
Jako účastník kurzu získáte přednostní přístup k jarní sadbě se slevou.
Hlavní benefity kurzu:
1. Celoroční systém pěstování
V kurzu se naučíte pěstovat šest pečlivě vybraných druhů hub, které vám zajistí sklizeň v průběhu celého roku:
- Hlíva ústřičná (podzim, zima, jaro)
- Hlíva buková (léto)
- Penízovka sametonohá (zima)
- Polnička topolová (konec léta, podzim)
- Reishi - lesklokorka lesklá (léto)
- Shiitake - houževnatec jedlý (jaro, podzim, léto)


2. Originální metody a vychytávky
Získáte přístup k unikátním postupům, které Jirka vyvinul během let experimentování:
- Speciální technika ochrany čel dřeva s "pokličkou"
- Metoda razidla pro ochranu kolíčků před hmyzem
- Optimální kombinace tvrdého a měkkého dřeva pro rozložení sklizně
- Použití vápna pro zvýšení počtu vln plodnosti
- Efektivní způsoby voskování pomocí stříkačky
3. Různé metody pro různé podmínky
Kurz vás naučí několik různých přístupů k pěstování, abyste si mohli vybrat ten, který nejlépe vyhovuje vašim podmínkám:
- Venkovní pěstování "na divoko" (na stojato nebo na ležato)
- Kontrolované pěstování v pytli
- Pěstování ve sklepě nebo jiných vnitřních prostorách
- Divoké pěstování na pařezech v lese


4. Kompletní systém od A do Z
Kurz vás provede celým procesem pěstování krok za krokem:
- Jak vybrat správné dřevo (druh, stáří, tloušťka)
- Jak zaočkovat kládu různými metodami (kolíčky, zrno)
- Jak umístit a pečovat o kládu v různých podmínkách
- Jak maximalizovat plodnost a předejít běžným problémům
- Jak pečovat o kládu v průběhu celého roku
5. Minimální investice, maximální výnos
- Pěstování hub nevyžaduje žádné speciální nebo drahé vybavení
- Z jedné klády můžete získat 5-10 kg kvalitních hub
- Správně připravená kláda může plodit 3-8 let (u pařezů až 10 let)
- Návratnost investice je několikanásobná


6. Praktické tipy pro vyšší úspěšnost
- Jak se vyhnout napadení klády hmyzem a slimáky
- Jak správně zavoskovat díry s kolíčky
- Jak udržet optimální vlhkost klády
- Jak aktivně ovlivnit plodnost některých druhů hub
- Jak řešit nejčastější problémy při pěstování
Jako účastník kurzu získáte přednostní přístup k jarní sadbě se slevou.
Co všechno v kurzu získáte
1. Video lekce s praktickými ukázkami
Kurz "Od špalku ke sklizni" obsahuje 20+ videí rozdělených do 4 modulů, kde Jirka názorně předvádí všechny postupy přímo v praxi. Uvidíte každý krok procesu v detailních záběrech.

2. Kompletní 43stránkový PDF přepis kurzu
Kromě videí získáte také podrobný PDF průvodce se všemi postupy, triky a technikami. Tento praktický manuál obsahuje:
- Detailní popis všech metod pěstování
- Přehledné fotografie jednotlivých kroků
- Sezónní kalendář péče o houby
- Tabulky s přehledem vhodných dřevin pro různé druhy hub
- Návody na řešení běžných problémů

3. Emailová podpora v průběhu kurzu
Po zakoupení kurzu budete dostávat pravidelné emaily, které vás provedou celým procesem pěstování. Tyto emaily obsahují:
- Připomenutí klíčových bodů z lekcí
- Doplňující tipy a triky
- Odpovědi na nejčastější otázky
- Motivační příběhy a inspiraci

4. Přístup ke kurzu na 2 roky
Jakmile kurz zakoupíte, máte k němu přístup po dobu 2 let. Během této doby se můžete k materiálům vracet kdykoli potřebujete a získáte také přístup ke všem aktualizacím a vylepšením kurzu vydaným v tomto období. PDF manuál si můžete stáhnout a ten vám zůstane natrvalo.


5. Bonus ve variantě Hlubšího poznání: Přednáška "Fascinující svět hub"
V 90minutové přednášce Jirka odhaluje tajemství hub, které běžně nepoznáte:
Samostatná říše hub - Proč houby nejsou ani rostliny, ani živočichové a jak přežily všechny katastrofy
Čaga - carevna ruské medicíny - Houba s 400 000 ORAC pro očistu organismu
Reishi pro kvalitní spánek - Jak prohlubuje REM fáze a podporuje regeneraci
Outkovka a její využití - Základ 90% všech lékopisů na nejrůznější nemoci
Tajemství houbového koření - Jirkova směs 13 druhů divokých hub
Praktické způsoby zpracování- Jak správně sušit a mlít houby pro maximum účinných látek
Jako účastník kurzu získáte přednostní přístup k jarní sadbě se slevou.
Obsah kurzu
Kurz "Od špalku ke sklizni"
OBSAHUJE 16. LEKCÍ
to je víc jak 20 videí rozdělených do 4 modulů + Bonusy (varianta hlubší poznání):
1. MODUL ZÁKLADY
1. LEKCE: Úvod do pěstování hub (06:37 min.)
2. LEKCE: Volba způsobu pěstování (09:33 min.)
3. LEKCE: Výběr správné houby a klády (06:03 min.)
- Hlíva Ústřičná popis (02:57 min.)
- Hlíva Buková popis (01:43 min.)
- Penízovka Sametonohá popis (02:01 min.)
- Polnička Topolová popis (01:32 min.)
- Shitake popis (01:45 min.)
- Reishi popis (02:27 min.)
4. LEKCE: Výběr dřeva (09:31 min.)

2. MODUL OČKOVÁNÍ
5. LEKCE: Příprava sadby a materiálu (02:50 min.)
6. LEKCE: Očkování kolíčky
- Očkování kolíčky buk (05:22 min.)
- Očkování kolíčky třešeň (03:20 min.)
7. LEKCE: Očkování čel
- Očkování čel třešně zrnitou sadbou (04:58 min.)
- Očkování čel buku kolíčky (03:11 min.)
8. LEKCE: Voskování
- Voskování třešeň (03:16 min.)
- Voskování buk (01:07 min.)

3. MODUL
UMÍSTĚNÍ A PÉČE
9. LEKCE: Umístění klády na stojato (02:17 min.)
10. lekce: Péče o kládu na stojato (08:29 min.)
11. lekce: Umístění klády na ležato (07:00 min.)
12. lekce: Péče o kládu na ležato (04:41 min.)

4. MODUL
DALŠÍ METODY
13. LEKCE: Pěstování v pytli (09:33 min.)
14. LEKCE: Pěstování hub ve sklepě (07:11 min.)
15. LEKCE: Divoké pěstování na pařezech (04:18 min.)
16. LEKCE: Závěrečná řeč (03:45 min.)

+ VARIANTA HLUBŠÍ POZNÁNÍ
OBSAHUJE
DOKUMENTÁRNÍ PŘÍBĚH JIRKY ŠŤÁSKA (40 min.)
PŘEDNÁŠKA FASCINUJÍCÍ SVĚT HUB (1 hod. 40 min.)
ZÁZNAM Z ŽIVÉHO VYSÍLÁNÍ S OTÁZKAMI NA JIRKU (1 hod.)

Vyberte si svou cestu k houbové zahradě
- Všechna výuková videa
- PDF manuál
-Všechny speciální bonusy
- 10% sleva na sadbu
přístup na 2 roky
100% garance spokojenosti do 14 dnů
- Přednáška fascinující své hub
- Záznam ze 60 min. konzultace postupů
- Dokument Žít lehce o Jirkovi
- Garance dostupnosti sadby
- 20% sleva na sadbu
přístup na 2 roky
100% garance spokojenosti do 14 dnů
Nejčastější dotazy při nákupu
Kdy dostanu přístup ke kurzu?
Ihned po platbě vám přijdou přístupy do členské sekce, kde najdete se všech lekcí.
Co když nebudu s kurzem spokojený?
Máte 14denní garanci vrácení peněz bez otázek. To je přesně doba, kdy budete mít za sebou víc jak polovinu kurzu a budete vědět jestli jste spokojeni.
Potřebuji nějaké speciální vybavení?
Ne, pro pěstování hub potřebujete jen běžné nářadí, které většina lidí má doma - vrtačku, kladívko a pilu. Žádné speciální nebo drahé vybavení není potřeba.
Odkud získám sadbu?
V kurzu se dozvíte, jak poznat kvalitní sadbu a kde ji získat. Účastníci kurzu mají za zvýhodněnou cenu možnost získat slevu na sadbu přímo od Jirky.
Je pěstování hub složité?
S našimi postupy ne. Kurz vás provede celým procesem krok za krokem, od výběru dřeva až po sklizeň. Naše metody jsou navrženy tak, aby fungovaly i začátečníkům.
Jak probíhá platba?
Platbu můžete provést online kartou nebo převodem. Používáme zabezpečený platební systém GoPay.
Jak dlouho trvá, než začnou houby růst?
Záleží na druhu houby a typu dřeva. Některé druhy na měkkém dřevě mohou začít plodit již za 4-6 měsíců, zatímco u tvrdšího dřeva může první sklizeň přijít až za rok nebo déle. V kurzu se dozvíte přesné časové horizonty pro každý druh houby.
Mohu pěstovat houby, i když nemám zahradu?
Ano, houby lze pěstovat i na balkoně, terase nebo dokonce ve sklepě. V kurzu se dozvíte o různých metodách pěstování
Je PDF manuál stejný jako obsah videí?
PDF manuál (43 stran) obsahuje veškeré informace z videí v přehledné textové podobě doplněné o fotografie. Je to skvělý doplněk k videím, který vám umožní rychle najít konkrétní informace bez nutnosti procházet celé video. Mnoho studentů si manuál tiskne a bere s sebou přímo k houbovým kládám jako praktickou příručku.
Proč začít právě teď?
Jaro je klíčové období pro start:
- Teploty se blíží ideálním 15°C pro očkování
- Jaro je období vláhy a ta je potřebná pro růst hub
- Garantovaná dostupnost jarní sadby jen pro účastníky kurzu
S námi se nemáte čeho bát
Jdeme do toho společně. Chceme, abyste měli jistotu, že:
• Sadba pochází přímo z Jirkovy laboratoře
• Máte přístup k technické podpoře během celého kurzu
• Všechny materiály zůstávají dostupné i po skončení kurzu
• Vrátíme vám peníze do 14 dnů, pokud nebudete spokojeni
Pokud po zakoupení nebudete spokojeni,
napište nám do 14 dnů na info@zitlehce.cz a my vám všechny peníze vrátíme. Za příběhy i kurzy si stojíme a víme z reací diváků, že se libí a pomáhají inspirovat na vaší cestě životem.
Nikdy nepředáme ani neprodáme Vaše osobní údaje a kontaktní informace třetí straně.
V případě, že máte jakékoliv otázky, neváhejte nás kontaktovat na e-mailu info@zitlehce.cz
Vaše platba je 100% zabezpečena a probíhá přes ověřenou platební bránu Stripe s šifrováním SSL.